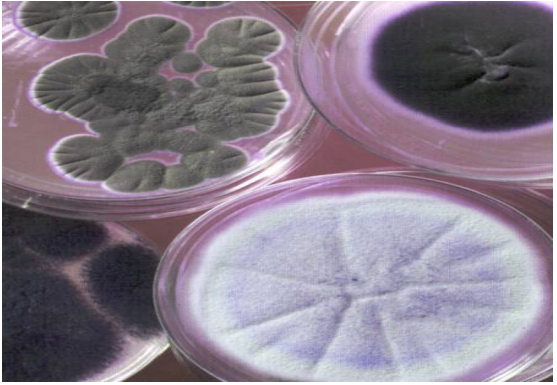

الفاكهة والاشجار المثمرة
الفاكهة والاشجار المثمرة
 نخيل التمر
نخيل التمر
 الحمضيات
الحمضيات 
 الاشجار ذات النواة الحجرية
الاشجار ذات النواة الحجرية
 المحاصيل
المحاصيل
 المحاصيل البقولية
المحاصيل البقولية
 محاصيل الالياف
محاصيل الالياف
 محاصيل زيتية
محاصيل زيتية
 محاصيل الحبوب
محاصيل الحبوب 
 محاصيل الخضر
محاصيل الخضر
 القرعيات
القرعيات 
 المحاصيل المنبهة و المحاصيل المخدرة
المحاصيل المنبهة و المحاصيل المخدرة
 المحاصيل السكرية
المحاصيل السكرية 
 نباتات الزينة والنباتات الطبية والعطرية
نباتات الزينة والنباتات الطبية والعطرية
 الحشرات النافعة
الحشرات النافعة
 النحل
النحل 
 دودة القز(الحرير)
دودة القز(الحرير)
 تقنيات زراعية
تقنيات زراعية
 التصنيع الزراعي
التصنيع الزراعي 
 الانتاج الحيواني
الانتاج الحيواني 
 الطيور الداجنة
الطيور الداجنة
 الاسماك
الاسماك
 الابقار والجاموس
الابقار والجاموس
 الاغنام
الاغنام 
 آفات وامراض النبات وطرق مكافحتها
آفات وامراض النبات وطرق مكافحتها 
 الحشرات
الحشرات 
 امراض النبات ومسبباتها
امراض النبات ومسبباتها 
 الحشائش والنباتات الضارة
الحشائش والنباتات الضارة |
أقرأ أيضاً
التاريخ: 6-6-2022
التاريخ: 10-6-2022
التاريخ: 14-6-2022
التاريخ: 17-8-2016
|
الاحياء المجهرية بالحليب
توجد الاحياء المجهرية في كل مكان، إذ تنتشر في الهواء والماء والتربة، على الحيوانات وحتى على الانسان. بعضها مفيد مثل التي تستخدم في تصنيع منتجات الالبان ومنتجات اللحوم، وبعضها يسبب تلف المواد الغذائية وقليل منها مرضية او مؤذية والتي يمكن ان تسبب امراض مثل الامراض المنقولة بالغذاء.
توجد ثلاثة انواع من الاحياء المجهرية يمكنها تلويث الغذاء وإحداث الامراض المنقولة وهي البكتريا والفايروسات والطفيليات، كما ان هناك مجموعة اخرى من الاحياء المجهرية والتي تؤخذ بالحسبان وهي الخمائر والاعفان وهذه تسبب فساد الغذاء ولكن لا تسبب الامراض عن طريق الغذاء.
يعد الحليب وسط جيد لنمو الكثير من اجناس الكائنات المجهرية كالبكتريا وبعض الاحياء المجهرية الاخرى كالخمائر والعفن. ما ان تحل هذه الاحياء في الحليب حتى تنشط وتتكاثر بسرعة كبيرة عند توفر درجة الحرارة الملائمة لها.
يحتوي الحليب على جميع المواد الغذائية الضرورية لنمو الاحياء المجهرية مثل سكر اللاكتوز والبروتين الذي يشمل الكازين فضلا عن الدهن والاملاح والفيتامينات.
ان عدد الاحياء المجهرية التي توجد في الحليب الصحي الطازج يكون قليلاً كما ان انواع هذه الاحياء يكون محدوداً نسبياً. الا ان مصادر التلوث العديدة التي تصاحب عملية الحلب والتداول والتصنيع ولحين وصول هذه المادة الى المستهلك تساهم بشكل او اخر بإضافة اعدادا وانواعا اخرى من الاحياء المجهرية الى الحليب.
أهمية دراسة الاحياء المجهرية:
إن الاهتمام بالأحياء المجهرية في الحليب ومنتجاته يرجع الى اهمية هذه المواد لأهميتها الغذائية واحتمال انتقال بعض الامراض الى الانسان بواسطتها.
يمكن تحديد أهمية دراسة الاحياء المجهرية في الحليب اعتمادا على النقاط الأتية:
1- ان معرفة محتويات الحليب من الاحياء المجهرية تساعد في تقييم السلامة الصحية والنوعية للحليب وظروف انتاجه.
2- ان السماح بنمو وتكاثر الاحياء المجهرية الموجودة في الحليب يؤدي الى حدوث تغييرات بايوكيمياوية كثيره قد تؤثر على نوعية الحليب وتجعله غير صالح للاستهلاك خاصة فيما إذا كانت هذه التغييرات كبيرة وغير مرغوب فيها.
3- الاستفادة من بعض انواع الاحياء المجهرية في صناعة بعض المنتجات مثل اللبن والجبن.
4- ان تلوث الحليب بالأحياء المجهرية قد يعني احتمال تلوثه بالمجهريات المسببة للأمراض الأمر الذي يلزم باتخاذ الاحتياطات الكفيلة للحد من حدوث هذه السلبيات وذلك بالاعتناء بالنظافة وتلافي حدوث تلوث للحليب. ومن اهم هذه الامراض الخطيرة التي تنتقل بواسطة الحليب او منتجاته هي:
1- التيفوئيد او الباراتيفوئيد.
2- الدزانتري.
3- السل.
4- الكوليرا.
تسبب هذه الاحياء عند نموها في وسط ما الكثير من التغيرات الكيمياوية والطبيعية كما هو الحال عند نموها على الانسان او الحيوان او النبات وتقسم هذه الاحياء الى:
1- الفايروسات Virus.
2- البكتريا Bacteria.
3- الفطريات Fungi.
4- البروتوزوا Protozoa.
البكتريا
تشكل البكتريا مجموعة الكائنات بدائية النوى تعامل معها الانسان دون ان يراها فقد عرف انها تسبب المرض واستعمل بعضها في عمليات تخمر مختلفة. ولقد كان لاكتشاف المجهر الاثر الكبير في التعرف عليها.
اول من اكتشف وجود البكتريا العالم الكيميائي الفرنسي (باستور) اذ اكتشف البكتريا الهوائية واللاهوائية من خلال تجاربه على التخمر وارتبط اسمه بعملية البسترة لقتل الكائنات الحية المجهرية التي يمكن ان توجد بالسوائل وخاصة الحليب.
اما العالم الالماني روبرت كوخ فقد أسهم في اكتشاف علاقة البكتريا بالمرض واول من عمل مزارع نقية للبكتريا.
ولقد ارتبط اسم البكتريا كثيراً بالأمراض التي تسببها للإنسان ولكن الاكتشافات الحديثة والتقدم السريع الذي حدث في العلوم التطبيقية اظهرت ان البكتريا تلعب دوراً هاماً في كثير من الصناعات الغذائية والدوائية والتخلص من المواد العضوية وغير العضوية وكذلك معالجة المياه العادمة والمعالجة الحيوية لمخلفات المزارع واستخدامها في انتاج الطاقة وغاز الميثان.
تتركب الخلية البكتيرية من الاجزاء التالية كما في شكل ادناه:
1- جدار الخلية The Cell Wall
2- المحفظة Capsule
3- غشاء السايتوبلازم Cytoplasmic Membrane
4- السايتوبلازم Cytoplasm: يمكن تقسيم المادة الخلوية داخل السايتوبلازم بين ثلاثة مناطق او أقسام:
أ- منطقة سيتوبلازمية حبيبية الشكل وغنية بمادة ال RNA.
ب- منطقة كروماتينية غنية بمادة الـ DNA.
ج- الجزء السائل الذي يحتوي على المواد الغذائية الذائبة.
5- النواة The Nucleus: وهي المنطقة الحاوية على المادة الوراثية للبكتريا.
6- تركيبات أخرى.
أ- الاسواط Flagella وتتواجد الاسواط حول الخلية البكتيرية.
ب- الاسواط القطبية في هذه الحالة تكون الخلية محتوية على سوط واحد واقع على احد قطبي الخلية او على كليهما.

شكل يبين الخلية البكتيرية
الصفات الشكلية للبكتريا:
تشتمل الصفات الشكلية للبكتريا على الصفات التالية
1- الشكل والترتيب: تتواجد الخلايا البكتيرية على الاشكال الاتية:
أ- الشكل الكروي (الدائري) Cocci.
تترتب الخلايا الكروية في خمسة ترتيبات هي كما في الشكل التالي

شكل يبين اشكال البكتريا الكروية
أولا- العنقودية ويكون ترتيبها مثل عنقود العنب. اي غير منتظم وتسمى Staphylococci.
ثانيا- السبحية قد تكون السلاسل طويلة او قصيرة وتسمى Streptococci.
ثالثا- المزدوجة وتكون في هذه الحالة كل خليتين مقابل بعضهما البعض وتسمى Diplococci.
رابعا- الرباعية وفي هذه الحالة تكون كل أربع خلايا مجتمعة مع بعضها البعض.
خامسا- الثمانية وهنا تكون كل ثمان خلايا مجتمعة على شكل مكعبات ثمانية.
ب- العصوية Bacilli: في العادة لا يكون للخلايا العصوية ترتيباً منتظماً، ولكن في احيان نادرة قد تترتب الخلايا العصوية على شكلين، ازواج وسلاسل كما في الشكل التالي.

شكل يبين البكتريا العصوية
2- تفاعل البكتريا مع صبغة الكرام: قسمت البكتريا على اساس تفاعلها مع صبغة غرام الى قسمين، قسم يتقبل صبغة غرام ويتلون بها ويسمى موجب التفاعل مع صبغة غرام Bacteria Positive Gram وقسم لا يتقبل صبغة غرام ويسمى سالب التفاعل مع صبغة غرام Negative Bacteria.
تكاثر البكتريا
تتكاثر خلايا البكتريا أما بالانقسام او ما يدعى بالانشطار البسيط اذ تكون الخلية الواحدة خليتين مستقلتين تحتوي كل واحدة منها على جميع العوامل كما في الشكل التالي.

شكل يبين الانشطار البسيط للبكتريا
وقد تنقسم خلية البكتريا الواحدة بين خليتين كل 20-30 دقيقة حسب الظروف. والصفات العامة للخلية البكتيرية الاصلية.
ولهذا يتوقع ان يكون العدد هائلاً بعد 24 ساعة من التكاثر المستمر في درجات الحرارة الملائمة. ان معدل النمو لا يكون منتظماً او مطردا كالمعتاد لأن التغيرات الكيمياوية التي تحدث في الوسط الغذائي تجعل البيئة اقل ملائمة للنمو ومن الواضح ان البكتريا الموجودة في الحليب والمعروفة باسم ستربتوكوكس لاكتس Streptococcus Lactis لا تنمو عندما تزيد درجة الحموضة في الحليب عن 1% بينما تنتج البكتريا المعروفة باسم لاكتوباسليس بولكاريكس Lacatobacillus bulgaricus نحو5 .2 % حموضة في الحليب قبل ان تتوقف عن النمو.
تقسيم البكتريا
يمكن تقسيم البكتريا بين ثلاثة انواع من حيث درجات الحرارة التي تناسب نموها: -
1- البكتريا التي تتحمل درجات الحرارة الواطئة وهي التي تستطيع النمو في درجات حرارة اقل من 10 درجة سليزية ويطلق عليها البكتريا المحبة للبرودة.
2- البكتريا التي توافقها درجات الحرارة الاعتيادية اذ تتكاثر في درجات تتراوح ما بين 10 - 45 درجة سليزية.
3- البكتريا المحبة للحرارة والتي تستطيع النمو والتكاثر في درجات الحرارة العالية نوعا ما بين 45-70 درجة سليزية.
وبصورة عامة يمكن ايقاف نمو البكتريا في الحليب لمدة لا تزيد على بضعة ايام إذا ما برد الحليب لدرجة 4 درجة سليزية. وعلى الرغم من ان نمو البكتريا يكون أشده في درجة الحرارة المثلى لكل نوع لكن يستطيع ان يعيش في درجات الحرارة الاخرى ولكن بصورة بطيئة.
ويمكن تقسيم البكتريا المتوطنة في الحليب حسب احتياجاتها الى الاوكسجين عند النمو والتكاثر بين انواع، منها انواع تنمو وتتكاثر جيداً بوجود الهواء ويطلق عليها بكتريا هوائية، بينما توجد انواع تنمو وتتكاثر في محيط خال من الهواء ويطلق عليها بكتريا لا هوائية.
اما الانواع التي تستطيع النمو والتكاثر في وجود الهواء او في عدمه فيطلق عليها بكتريا اختيارية.
البكتريا المنتجة للحامض
يطلق على هذه المجموعة بكتريا حامض اللاكتيك وهي كروية الشكل وتوجد على شكل سلاسل او ثنائية وهي متجانسة التخمر اذ يكون حامض اللاكتيك الناتج الرئيسي من تخمر سكر اللاكتوز ومن أشهر هذه المجموعة واكثرها انتشاراً في الحليب هي بكتريا Lactococcus lactis و Lactococcus cremoris المسؤولتين عادة عن حموضة الحليب الخام.
ان درجة الحرارة المثلى لنموها هي 20-30 درجة سليزية ولها القابلية على النمو في درجات حرارة اوطأ (10-15 درجة سليزية)، وعلى درجات حرارة اوطأ قد تصل 4 درجة سليزية. وتعد هذه البكتريا من اهم الانواع المنتجة لحامض اللاكتيك واكثرها انتشاراً وتوجد حيث يوجد الحليب ومنتجاته، وهي السبب الرئيسي في اتلاف كميات كبيرة من الحليب سنوياً ويسهل اتلافها بالحرارة وعند ارتفاع الحموضة.
ان مصدر هذه البكتريا ليس داخل الضرع انما توجد في آنية الحليب والاقذار العالقة بالحيوان وفي بعض الاغذية كالسبانغ وهذه غير مرضية. وقد تكون غير متجانسة التخمير مثل Leuconostic mesenteroides الهامة في صناعة الزبد وبالأخص لتكوين النكهة، وهذه تنتج عند تخمير اللاكتوز اقل من 50 % حامض اللاكتيك اما المواد الاخرى الناتجة فهي مركبات مختلفة.
وهناك الانواع العصوية المسماة Lactobaclli ومنها Lactobacillu sacidophilus التي تنمو بدرجة 45 درجة سليزية وهي تستخدم في صناعة بعض المتخمرات من الحليب الاسيدوفليس. وتكون افراد هذه المجموعة واسعة الانتشار في الطبيعة، وتوجد في العلف وبراز الحيوان والحليب ومنتجاته.
وتعد بكتريا القولون Coliform من الناحية البيوكيمياوية فعالة جداً، اذ تخمر سكر اللاكتوز منتجة حامض اللاكتيك وحامض الخليك وكميات قليلة من حوامض اخرى. تصل افراد هذه المجموعة الى الحليب من مصادر متعددة كالبراز والماء الملوث والتربة وغيرها.
ان وجود هذه البكتريا في الحليب يعد دليلاً على التلوث اما من مصدر حيواتي (برازي) ويدل عليه وجود بكتريا E. coli او من التربة او النباتات. وان وجدت في الحليب المبستر تعد دليلاً على عدم كفاءة عمليات البسترة او ان تلوثاً اصاب الحليب بعد عملية البسترة. ان كمية الحامض الذي تنتجه هذه البكتريا يكون كافٍ لترسيب الكازين. ان وجود بكتريا القولون في الحليب ومنتجاته يؤخذ كدليل على تواجد البكتريا المرضية الاخرى مثل بكتريا السالمونيلا Salmonella التي تسبب مرض التيفوئيد وبكتريا الـ Shigella التي تسبب الزحار العصوي.
البكتريا المنتجة للغازات:
كثير من الاحياء المجهرية لها القدرة على تخمير المواد الكربوهيدراتية وانتاج الغاز جنباً الى جنب مع الحامض. فبكتريا القولون وبكتريا جنس الكلوسترديوم Clostridium تنتج كميات كبيرة من ثاني اوكسيد الكاربون والهيدروجين نتيجة لتخمر سكر اللاكتوز وكذلك بالنسبة للعديد من الخمائر. ان كمية الغازات المتكونة تتباين معاً لعدد وانواع الاحياء المجهرية وقد تكون بدرجة تؤدي الى رفع أغطية دبات الحليب. ان تكون الغازات ليس مقصوراً على الحليب فقط وإنما قد يحدث كذلك في القشطة والاجبان ومنتجات الالبان الاخرى.
الحليب اللزج (الخيطي) Fermentation Ropy
عند حدوث مثل هذا التخمر يتغير تركيب الحليب بحيث تلتصق اجزاؤه ببعضها فتزداد لزوجته الى درجة يمكن سحب خيوط منه ويعتمد ذلك درجة التلوث والتخمر، وإذا وجد تخمر لاكتيكي في نفس الوقت فان الحليب يصبح كالعجينة. وفي بعض الاحيان تختفي اللزوجة عند ازدياد الحامض وفي أحيان اخرى تزداد وعند تحريكه بشدة فأن اللزوجة تقل. ومن اهم البكتريا المسببة لهذا التخمر هي Alcaligens viscolactis ويكثر وجودها في الماء حول الاصطبلات وفي اواني الحليب الحاوية على ماء او التي غسلت بماء ملوث، لذلك يجب الاهتمام بتعقيم الاواني وتنظيف الاصطبلات. ان ظاهرة انتاج الحليب اللزج تدعى Ropiness.
تحليل البروتين
ان تخثر بروتينات الحليب لا يحدث فقط عند ارتفاع الحموضة وانما قد يحدث بسبب الانزيمات المحللة للبروتينات وعندما تكون حموضة الحليب اعتيادية. أن هذه الانزيمات المشابهة لأنزيم الرنين تفرز من قبل أحياء مجهرية معينة وتعمل على بروتينات الكازين مسببة تخثرها ان عملية التخثر تكون مصحوبة اعتيادياً بتحلل وهضم البروتينات واعتماداً على نوع الاحياء المجهرية والانزيمات المفروزة. ومن نتائج هذا النوع هو تحليل البروتين اذ يصاحبه تراكم كميات مختلفة من النواتج النتروجينية الذائبة التي تسبب خفض حموضة الحليب واعطاء المذاق المر له.
ولا يحدث هذا التخمر إلا قليلاً ويحصل خصوصاً في الحليب المبستر الذي خزن وقتاً طويلاً وفي المواسم الحارة ومن أهم البكتريا المسببة هيBacillus subtilis .
Bacillus coagulans كما تتمكن بعض الخمائر والاعفان من انتاج التخثر عند تلويثه للحليب. ان اهم مصدر لتلوث الحليب المبستر والمعقم بهذه الاحياء هي الاواني والاجهزة غير المعقمة علاوة على الاعلاف والتربة.
يحدث هذا التجبن عادة في الحليب المبستر والحليب المعقم، وقد يحدث ذلك احياناً في الحليب الخام المحفوظ على درجات حرارة منخفضة (10 درجة سليزية).
تحليل الدهون Lipolysis
يحدث مثل هذا التغير في الحليب اما بسبب انزيم اللايبيز الموجود بصورة طبيعية بالحليب الطازج ولكن يتلف بالبسترة او قد ينتج بفعل البكتريا، ويؤدي هذا التحلل الى ظهور التزنخ Rancidity وتنمو البكتريا المسببة لهذا التحلل في درجات واطئة بين 4-10 درجة سليزية اذ لا تزحمها بكتريا حامض اللاكتيك ومن أهم البكتريا:
Pseudomonas flurescans frag
وقد تنتج بعض البكتريا المشابهة طعماً مؤكسداً بالحليب بسبب افرازها لأنزيم الاوكسيديز فيؤدي الى تأكسد الاحماض الدهنية غير المشبعة في مواضع الروابط المزدوجة.
الخمائر والاعفان
الاعفان هي فطريات مجهرية يمكن ان تعيش على النباتات والحيوانات كما ان اغلب الاعفان تفسد الاغذية، كونها منتشرة بصورة كبيرة في الطبيعة ويلاحظ نموه دائماً على الخبز عند تركه لمدة ايام في درجة حرارة الغرفة مع قليل من الرطوبة.
بعضها يكون سموم والتي يمكن ان تسبب الامراض، ويمكنها ان تنمو في الاغذية التي حموضتها عالية ورطوبتها قليلة، ولكنها تحتاج الى الهواء كي تنمو.
العفن من الفطريات كثيرة الخلايا ويقع في رتبة النباتات التي لا تملك سيقاناً او جذور او اوراق ولا تملك مادة الكلوروفيل كما في الشكل التالي.

شكل يبين العفن
أن أغلب الاعفان منتجة للسبورات، هذه السبورات يمكن ان تنتقل بواسطة الهواء والماء والحشرات.
وعند جفاف السبورات يمكن ان يحملها الهواء وتنمو من جديد عند توفر الظروف المناسبة، وعلى الرغم من ان معظم الاعفان تحب درجات الحرارة الدافئة لكنها تتمكن من النمو في درجة حرارة الثلاجة (5 درجة سليزية) او ابرد، تتحمل الاعفان الملح والسكر وكذلك تنمو في قناني المربى المفتوحة وكذلك الجلي وعلى اللحوم المقددة المالحة.
تمتلك الاعفان تفرعات وجذور والتي تشبه الخيوط الرقيقة، ربما من الصعوبة رؤية الجذور عندما ينمو العفن على الغذاء وربما تكون هذه الجذور متعمقة في الغذاء ولهذا عندما يرى العفن في الغذاء فيجب التخلص من كل الغذاء وليس فقط من الجزء المتعفن.
ويتصف العفن بالألوان المختلفة فمنه الابيض القطني والاسود والاخضر كما في الشكل التالي، ويستعمل العفن في الالبان في إنضاج بعض انواع الجبن كما هو الحال في جبن الروكفورت وانواع الكاممبرت.
شكل انواع الاعفان
اما الخمائر فهي شكل آخر من اشكال الفطريات توجد بصورة عامة في النباتات والحبوب والفواكه وبعض الاغذية الاخرى المحتوية على السكر. تتواجد الخمائر في التربة والهواء وعلى الجلد وفي امعاء الحيوانات. تنتقل الخمائر من مكان الى اخر بواسطة الاشخاص والمعدات والتيارات الهوائية. تسبب الخمائر تلف الغذاء ولكنها لا تسبب امراض عن طريق الغذاء.
تتميز الخمائر بكبر حجم خلاياها وهي ذات خلية واحدة واغلبها أكبر حجماً من انواع البكتريا كما في الشكل التالي. وتستعمل الخميرة في صناعة الخبز والصمون اذ تتحول الى عجينة يستسيغها الانسان ويكبر حجمها عند خبزها، كما تستعمل في صناعة الكحول والنبيذ.
تسبب بعض انواع الخمائر اللون الاحمر في الحليب كما ان بعض انواعها يسبب ظهور الغازات في الحليب ومنتجاته.

شكل الخمائر
تتصف الخمائر بعدم مقاومتها للحرارة، لذا فأن درجات الحرارة المستعملة في البسترة تقضي عليها. واهمية الخمائر في صناعة الالبان محدودة وقد تستعمل في صناعة بعض الالبان المتخمرة.
ومن المعروف ان الاعفان والخمائر تنمو جيداً في الوسط الحامضي كما يشاهد ذلك عند ترك الحليب في درجة حرارة الغرفة اذ ترتفع نسبة الحموضة فيه نتيجة لنمو البكتريا وبعدها تبتدئ الخمائر او العفن بالنشاط والتكاثر وتنتج حينذاك ظواهر التلف، وعندما تأخذ الحموضة بالنقصان نتيجة نمو العفن تنشط انواع اخرى من البكتريا التي تقوم بتحليل البروتين.
مصادر الاحياء المجهرية في الحليب
أن شدة تلوث الحليب يعتمد مصدر الحليب ففي:
1- الحليب المأخوذ من ابقار سليمة وتحت أفضل وأسلم الظروف الصحية في انتاجه، يحتوي على احياء مجهرية سبق وان دخلت الى ضرع الحيوان عن طريق فتحات الحلمات وقنوات الحليب. ان هذه الاحياء والتي تكون اعتيادياً (بكتريا غير ضارة ومن النوع الكروي، تدفع خارجاً) خلال عملية الحلب.
وان اعداد هذه الاحياء المجهرية في وقت الحلب يتراوح من بضع مئات الى آلاف في المللتر الواحد وتختلف هذه الاعداد من بقرة الى اخرى. وكذلك بين أرباع الضرع للحيوان نفسه وتبعاً للظروف الصعبة المتبعة في إنتاج الحليب. وتكون اعدادها أكبر خلال المراحل الاولى لعملية الحلب.
2- أما بالنسبة للحيوانات المريضة فتكون أعداد البكتريا فيها أكبر مع احتمال ان يكون بعضها مرضياً للإنسان مثل بكتريا السل، او بكتريا الاجهاض المعدي أو أية مسببات مرضية اخرى تصيب الحيوان لذلك فأن مراقبة الحيوانات وفحصها بصورة مستمرة يساعد على التخلص من هذه الاصابات، وعليه يجب ان تُستبعد الحيوانات المصابة عن القطيع. كما يساهم جلد الحيوان بتلويث الحليب. لذا يجب ان يكون نظيفاً ويفضل ان يغسل الضرع والحلمات بواسطة محاليل مطهرة وتجفف قبل عملية الحلب.
3- يمكن ان يساهم المحلب (مكان الحلب) في زيادة الاحياء المجهرية في الحليب. فتتجمع الاوساخ وبراز الحيوانات والتي تساعد في زيادة اعداد الاحياء المجهرية في جو المحلب الذي بدوره يلوث الحليب. عليه يجب تجنب آثار الغبار خلال عملية الحلب، كما ان تصميم المحلب يجب ان يكون بشكل يسمح بالإضاءة والتهوية الجيدة وان تكون أرضيته من السمنت ليسهل غسلها وتنظيفها.
4- اواني الحليب تعد من المصادر الاخرى الهامة جداً لتلوث الحليب. اذ إن إهمال هذه الأواني وعدم تنظيفها بصورة صحيحة يساعد كثيراً في زيادة عدد المجهريات الملوثة للحليب. ان الطريقة الصحية لمعاملة مثل هذه الادوات هي شطفها جيداً بالماء البارد بعد الاستعمال مباشرة، ثم غسلها بماء ساخن يحتوي على المنظفات، ثم شطفها بكميات كبيرة من الماء الحار. بعد ذلك تعقم الاواني بواسطة الهواء الحار او البخار.
5- اما الاشخاص المسؤولين عن عملية الحلب وتداول الحليب فمن الممكن ان يكونوا مصدر آخر لتلوث الحليب. عليه يجب ان يكون مثل هؤلاء الاشخاص ملمين بالظروف الواجب توفرها لإنتاج حليب صحي وان يكونوا سالمين من الامراض وغير حاملين للمكروبات.
لذا يتبين ان الحليب (بعد انتاجه) يكون عرضة الى التلوث من مصادر كثيرة ولحين تصنيعه وايصاله الى المستهلك. لذا يجب السيطرة على ظروف تداول وتصنيع الحليب من الناحية الصحية.
الفعل المطهر للحليب
يعد الحليب مصدراً خصباً لنمو وتكاثر المجهريات وذلك لقيمته الغذائية العالية. وان له تأثير مثبط او مانع لنمو المجهريات. فقد لاحظ العديد من الباحثين بان البكتريا لا تنمو بشكل جيد في الحليب الحديث الحلب. ان هذا التأثير المثبط او المانع لنمو البكتريا يختلف باختلاف مصادر الحليب نفسه ويبقى لعدد من الساعات بعد عملية الحلب قد تصل المدة الى 24 ساعة فيما إذا احتفظ بالحليب تحت ظروف التبريد. ان سبب التأثير المثبط او المانع لنمو البكتريا هو اللاكتنين Lactinine الذي تم عزله من الحليب ووجد بأنه يتكون من مركبين متكافئين هما لاكتنين (1) ولاكتنين (2). الاول يتواجد في الحليب واللبأ والثاني في الحليب الطبيعي. ان نشاط اللاكتنين يتوقف في حالات الظروف اللاهوائية لذلك يكون تأثيره محدود في داخل الضرع ومجمعات الحليب. ان لنشاط اللاكتنين وتأثيره المانع لنمو البكتريا ليس له اهمية عملية ملموسة. اذ ان التطور التكنولوجي في انتاج الحليب (تبريد الحليب بعد الانتاج) ادى الى ضمور أهمية اللاكتنين العملية.



|
|
|
|
التوتر والسرطان.. علماء يحذرون من "صلة خطيرة"
|
|
|
|
|
|
|
مرآة السيارة: مدى دقة عكسها للصورة الصحيحة
|
|
|
|
|
|
|
نحو شراكة وطنية متكاملة.. الأمين العام للعتبة الحسينية يبحث مع وكيل وزارة الخارجية آفاق التعاون المؤسسي
|
|
|